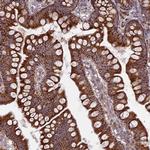
UAP1L1 Antibody in Immunohistochemistry (Paraffin) (IHC (P))

Search
Invitrogen
UAP1L1 Polyclonal Antibody
{{$productOrderCtrl.translations['antibody.pdp.commerceCard.promotion.promotions']}}
{{$productOrderCtrl.translations['antibody.pdp.commerceCard.promotion.viewpromo']}}
{{$productOrderCtrl.translations['antibody.pdp.commerceCard.promotion.promocode']}}: {{promo.promoCode}} {{promo.promoTitle}} {{promo.promoDescription}}. {{$productOrderCtrl.translations['antibody.pdp.commerceCard.promotion.learnmore']}}
产品信息
PA5-60688
种属反应
宿主/亚型
分类
类型
抗原
偶联物
形式
浓度
规格
纯化类型
保存液
内含物
保存条件
运输条件
RRID
产品详细信息
Immunogen sequence: SPNWTLDPEP RCRLWSEPRL PAGPGVLAAG SPRLPCRYVM TSEFTLGPTA EFFREHNFFH LDPANVVMFE QRLLPAVTFD GKVILER
Highest antigen sequence identity to the following orthologs: Mouse - 46%, Rat - 47%.
靶标信息
UAP1 is a 56KDa isoform which catalyzes the final step of UDP-N-acetylglucosamine (UDP-GlcNAc) biosynthesis from fructose-6-phosphate. UDP-GlcNAc, the activated form of GlcNAc moiety is used as a key precursor in N-linked glycosylation and the glycosylphosphatidylinositol (GPI)-anchor of cellular proteins. Crystallization studies revealed UAP1 is composed of a large central core flanked by two smaller extra domains. The central main domain displays a alpha/beta structure resembling the Rossmann fold. Northern Blot analysis detected abundant expression of UAP1 in testis and sperm with a low expression in placenta, muscle and liver. It is implicated in antibody-mediated infertility in males.
仅用于科研。不用于诊断过程。未经明确授权不得转售。
篇参考文献 (0)
生物信息学
蛋白别名: UAP1; UDP-N-acetylhexosamine pyrophosphorylase-like protein 1; UDP-N-acteylglucosamine pyrophosphorylase 1-like 1; unnamed protein product
基因别名: UAP1L1
UniProt ID: (Human) Q3KQV9
Entrez Gene ID: (Human) 91373